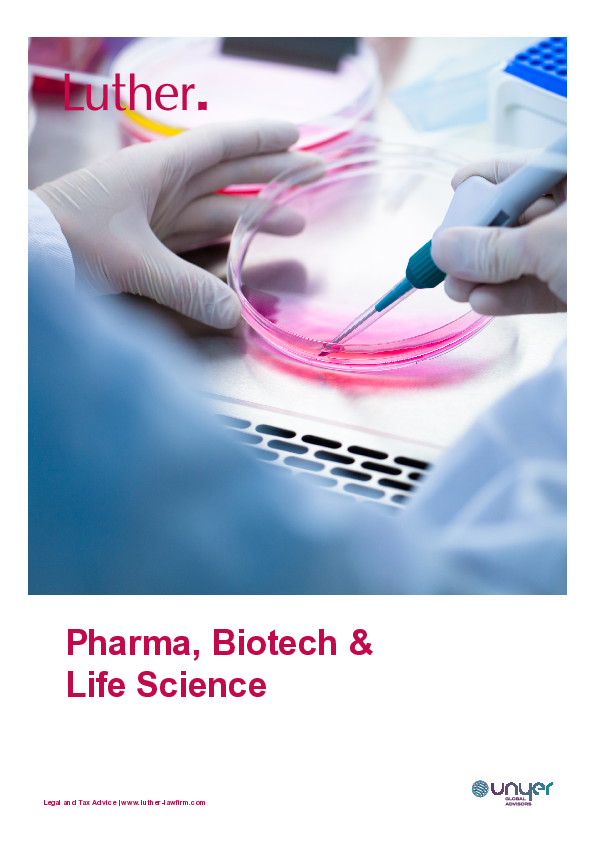
Information Tech & Telecommunications

Mit unseren spezialisierten Experten für IT Recht verwandeln wir Ihre Herausforderungen in Projekterfolge.
Unser Beratungsangebot
Unser auf die Lösung IT-rechtlicher Fragestellungen spezialisiertes Team verfügt über langjährige Erfahrung im Bereich „Information Tech und Telecoms“ und berät IT-Anbieter und Kunden unter Berücksichtigung ihrer besonderen Interessenlage und Anforderungen. Ob Künstliche Intelligenz, agiles Projektvorgehen, IT-Outsourcing, Lizenzgestaltung oder Industrie 4.0-Großvorhaben – mit unserem Technologie-Team entstehen die besten Lösungen für komplexe Probleme.
Wir unterstützen Sie, in enger Zusammenarbeit mit den Teams aus dem Gewerblichen Rechtsschutz und Urheberrecht sowie unserem Datenschutz-Team, bei der Erstellung und Verhandlung von Lizenzverträgen wie Softwarelizenzen, ASP-, SaaS- oder Cloud Computing-Verträgen. Wir haben auch umfangreiche Erfahrungen beim IT-Outsourcing, BPO, Transitional Services Agreements bis hin zu IT-Vergaben der öffentlichen Hand (EVB-IT Verträge).
Bei agilen Softwareprojekten sind wir mit den urheber- und vertragsrechtlichen Herausforderungen bei der Gestaltung der Verträge sowie den arbeitsrechtlichen Problemstellungen vertraut, um die Interessen von Auftraggeber oder Auftragnehmer optimal zu berücksichtigen.
Beim Einsatz auf Künstlicher Intelligenz (KI) basierender Systeme unterstützt unser Team Sie branchenunabhängig dabei, von den Fortschritten in KI zu profitieren und die aktuellen regulatorischen Anforderungen (KI-Verordnung) einzuhalten. Wir sind beim Einsatz von KI-Technologien, wie maschinelles Lernen und Deep Learning, mit den komplexen Fragen, unter anderem des Schutzes von Leistungsergebnissen sowie den Rechten zur Nutzung von Daten und der Haftung vertraut, um die Chancen und Risiken aus dem Einsatz von KI sachgerecht zu berücksichtigen.
Wenn gewünscht, begleiten wir Sie bei dem gesamten Prozess, angefangen von der Bedarfsanalyse über die Ausschreibung, die Vergabe, den Entwurf und die Verhandlung der Vertragsunterlagen und Leistungsbeschreibungen unter Berücksichtigung von arbeits- und lizenzrechtlichen Fragestellungen, IT-Security und Datenschutz-Themen sowie gegebenenfalls aufsichtsrechtlichen Anforderungen.
Im regulierten Bereich sowie bei Finanztechnologien (FinTech) beraten wir Unternehmen der Finanzbranche, Technologieanbieter und Anbieter neuer technologiegestützter Geschäftsmodelle zu innovativen Technologien und Digitalisierungsstrategien. Dies umfasst unter anderem die Strukturierung der Rechtsbeziehungen bei Plattformgeschäften oder elektronischen Marktplätzen, Identifizierungsdienstleistungen und Authentifizierungsanforderungen oder Zahlungsdienstleistungen. Wir liefern strategischen rechtlichen Input, um die erforderliche Compliance in einem stark regulierten rechtlichen Umfeld zu gewährleisten. Unsere Anwälte verstehen die technologischen Zusammenhänge etwa bei der Nutzung offener APIs und Open Banking Strukturen und bei der Nutzung mobiler Anwendungen und Bezahlsysteme einschließlich Near Field Communication Standard und gestalten Fragen des „data ownership“ interessengerecht.
Industrie 4.0-Vorhaben im Bereich der produzierenden Industrie begleiten wir etwa zur Vermarktung von Predictive Maintenance Services und zur intelligenten Steuerung und Vernetzung von Abläufen in der Smart Factory unter Nutzung des 5G Mobilfunkstandards. Dies ermöglicht Ihnen, die Wertschöpfungskette optimal zu gestalten.
- Entwurf und Verhandlung von Soft- und Hardware-Überlassungsverträgen
- Application Service Providing, Software-as-a-Service, Platform-as-a-Service oder Infrastructure-as-a Service Verträge
- Pflege- und Wartungsverträge
- Service Level Agreements (SLA)
- Projekt- und Dienstleistungsverträge zur Erstellung, Implementierung und zum Customizing von Software
- Escrow- und Hinterlegungsvereinbarungen
- Rechenzentrumsbetrieb und Shared Service Center
- Vertrieb von Hard- und Software (z.B. OEM-Vertrag, Enduser Licence Agreement, Re-Seller-Vertrag)
- Einsatz / Nutzung von Open Source Software und „gebrauchter“ Software
- Beratung und Vertragsgestaltung bei agilen Softwareentwicklungsprojekten
- Bedarfsanalyse und -feststellung unter Beachtung rechtlicher Fragestellungen (z. B. zum Datenschutz oder e-Government)
- Nachweis der Wirtschaftlichkeit vor und während der Beschaffungsmaßnahme
- IT-Ausschreibungen
- Auswahl und Anwendung der EVB-IT
- Prüfung von Leistungsbeschreibungen
- IT- und Business Process-Outsourcing sowie Projektverträge zu komplexen IT-Systemen
- Bedarfsanalyse und -feststellung unter Beachtung rechtlicher Fragestellungen (z. B. zum Datenschutz)
- Beratung zu Cloud Computing einschließlich Application Service Providing, Software-as-a-Service, Platform-as-a-Service, Infrastructure-as-a Service, Nearshoring und Offshoring
- Vertragsprüfung und -gestaltung
- Datenschutz
- Haftungsfragen
- Lizenzmanagement
- Umsetzung von Strategien zum Schutz von Geschäftsgeheimnissen
- Exit-Management
- Beratung zur Ausgliederung einzelner IT-Unternehmensbereiche in Tochterunternehmen sowie damit verbundene Themen (z. B. Rechte und Pflichten bei Betriebsübergang)
- Finanzaufsichtsrechtliche Vorgaben
- Rechtliche Grundlagen der IT-Sicherheit und IT-Compliance
- IT-Risikomanagement
- Beratung zur Umsetzung des IT-Sicherheitsgesetzes (z. B. KRITIS-Vorgaben für die Branchen Energie, Informationstechnik und Telekommunikation, Transport und Verkehr, Gesundheit, Wasserversorgung, Ernährung sowie Finanz- und Versicherungsrecht)
- Durchführung und Begleitung von Audits
- IT-Sicherheit im Arbeitsverhältnis, z. B. Entwurf von Betriebsvereinbarungen und Unternehmensregelungen zur Nutzung von E-Mail und Internet im Arbeitsverhältnis
- Rechtliche Begleitung von Cybersecurity-Vorfällen
- Entwurf von Allgemeinen Geschäfts-/ Nutzungsbedingungen und Datenschutzhinweisen für Shops, Portale und elektronische Plattformen/ Marktplätze
- Gestaltung von Bedingungen und Datenschutzhinweisen für Apps
- Überprüfung der Zulässigkeit von Geschäftsmodellen
- Beratung bei Identifizierungs- und Authentifizierungsleistungen (Video-Ident, E-Ident, Zweite Zahlungsdienste-Richtlinie)
- Beratung zu Zahlungsdienstleistungen
- Beratung zum Einsatz von Re-Targeting Werbe-Maßnahmen
- Beratung zu Lizenzmodellen, Lizenzkompatibilität, Haftung und Gewährleistung beim Einsatz von Open Source Software, Public Domain Software, Freeware, Shareware
- Gestaltung von Lizenzbedingungen
- Geltendmachung von und Verteidigung gegen Lizenzverletzungsansprüche(n)
- Beratung bei der Einführung eines Open Source Project Management
- Beratung zu Fragen der indirekten oder automatisierten Lizenznutzung
- Smart Contracts/ Blockchain basierte Leistungen
- Gestaltung von allgemeinen Geschäfts-/ Nutzungsbedingungen und Kooperations-/ Vertriebsverträgen für elektronische Plattformen/ Marktplätze
- Beratung zu Zahlungsdienstleistungen (e-Geld, Voucher)
- Vermögensanlage (einschließlich Robo-Advice)
- Big Data Anwendungen
- Gestaltung von Verträgen zur Auslagerung wesentlicher und nicht wesentlicher Funktionen
- Pre-Outsourcing Analyse, Due Diligence
- Interne Dokumentation
- Digital Operational Resilience Act im Finanzsektor
- Identifizierung von bereichsrelevanten Aufbewahrungs- und Löschfristen einschließlich der Beratung zur Zulässigkeit einer Aufbewahrung in digitaler Form
- Beratung bei der Anwendung einschlägiger Verjährungsfristen
- Beratung bei der technischen Umsetzung und zu den Anforderungen an die revisionssichere Archivierung (gemäß §§ 239, 257 HGB, §§ 146, 147 AO und den Grundsätzen zur ordnungsmäßigen Führung und Aufbewahrung von Büchern, Aufzeichnungen und Unterlagen in elektronischer Form sowie zum Datenzugriff (GoBD))